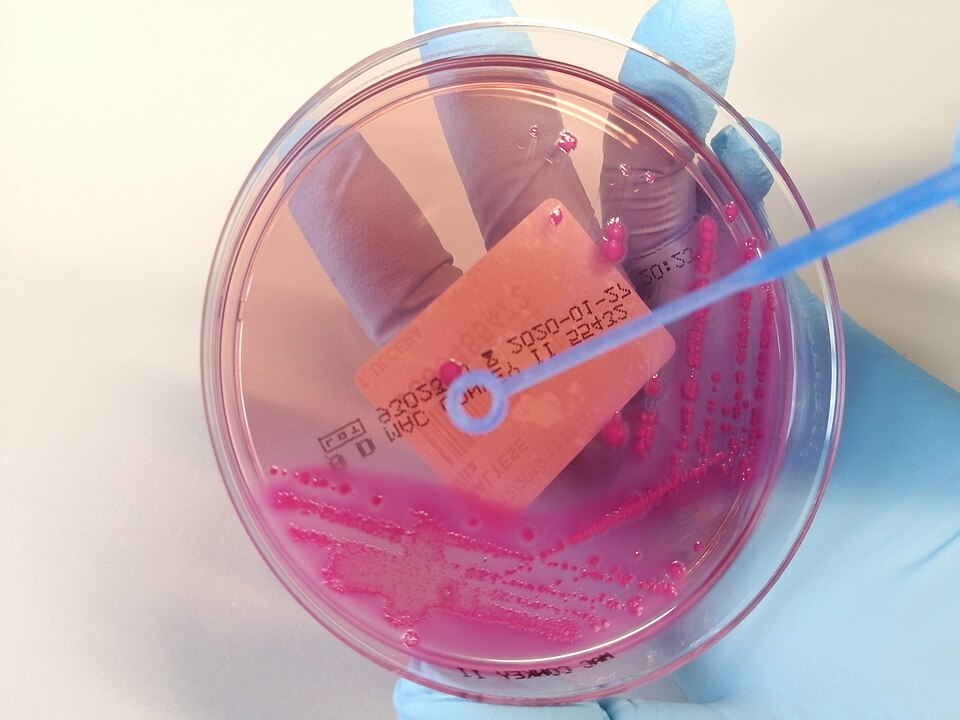
Microbiology

Home
Quest
Answered
Saved
Hot Topics
Following
Followers

Post
Create
Promote

Comments
Money
Account